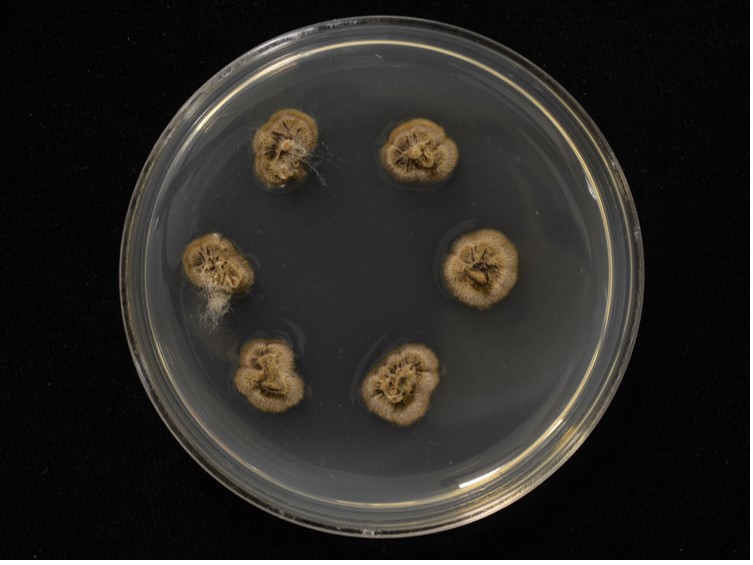

Holotype:
THAILAND, Nakhon Ratchasima Province, Khao Yai National Park, 27 Nov. 2013, S. Mongkolsamrit, P. Srikitikulchai, A. Khonsanit, W. Noisripoom, D. Thanakitpipattana, holotype BBH 38015, ex-type living culture TBRC 8093.
Habitat:
Underside of leaves.
Host:
Hemiptera.
Description:
 Stroma single, cylindrical and flexuous, arising from between the head and the thorax of host, brown-dark brown, 30-40 × 2 mm, unchanged in 3 % KOH.
Stroma single, cylindrical and flexuous, arising from between the head and the thorax of host, brown-dark brown, 30-40 × 2 mm, unchanged in 3 % KOH.  Perithecia superficial, sparse, up to 10, loosely aggregated, arising from middle part of stroma, ovoid with a distinct base, dark brown-black, 560-650 × 200-240 μm.
Perithecia superficial, sparse, up to 10, loosely aggregated, arising from middle part of stroma, ovoid with a distinct base, dark brown-black, 560-650 × 200-240 μm.  Asci hyaline, cylindrical, 8-spores, 250-320 × 10-15 μm, with thickened apical cap, 6-7 μm in diam.
Asci hyaline, cylindrical, 8-spores, 250-320 × 10-15 μm, with thickened apical cap, 6-7 μm in diam.  Ascospores hyaline, filiform, 220-300 × 3-5 μm, remain whole after discharge, multiseptate. Conidiogenous structures on the stroma in a discontinuous layer at the terminal end which arise perpendicular to the surface, brown. Conidiogenous cells monophialidic, hyaline, smooth. Phialides 14.5-19 μm, phialide base 8-13 × 4-5 μm, phialide neck 4.5-9 × 1 μm. Conidia hyaline, smooth, obovoid to falcate, 5-7 × 2-3 μm, embedded in a mucous sheath.
Ascospores hyaline, filiform, 220-300 × 3-5 μm, remain whole after discharge, multiseptate. Conidiogenous structures on the stroma in a discontinuous layer at the terminal end which arise perpendicular to the surface, brown. Conidiogenous cells monophialidic, hyaline, smooth. Phialides 14.5-19 μm, phialide base 8-13 × 4-5 μm, phialide neck 4.5-9 × 1 μm. Conidia hyaline, smooth, obovoid to falcate, 5-7 × 2-3 μm, embedded in a mucous sheath.
Culture characteristics:
Colonies on PDA growing very slowly, funiculose, attaining a diam of 12–14 mm within 20 d at 20 °C. Colonies orange grey to olive bearing conidiogenous cells and conidia of the Hirsutella asexual morph. Colony reverse dark brown after 30 d. Conidiogenous cells monophialidic, arising from hyphae laterally or terminally, hyaline, smooth, tapering gradually or abruptly into slender neck. Phialides, 30–50 μm, phialide base 16–35 × 3–4 μm, phialide neck 7–18 × 1 μm, rough and warty. Conidia hyaline, 1-celled, smooth-walled, lemon shaped to falcate, 6–9 × 3–4 μm, embedded in a mucous sheath. Chlamydospores not observed.
Colonies on PDA growing very slowly, funiculose, attaining a diam of 12–14 mm within 20 d at 20 °C. Colonies orange grey to olive bearing conidiogenous cells and conidia of the Hirsutella asexual morph. Colony reverse dark brown after 30 d. Conidiogenous cells monophialidic, arising from hyphae laterally or terminally, hyaline, smooth, tapering gradually or abruptly into slender neck. Phialides, 30–50 μm, phialide base 16–35 × 3–4 μm, phialide neck 7–18 × 1 μm, rough and warty. Conidia hyaline, 1-celled, smooth-walled, lemon shaped to falcate, 6–9 × 3–4 μm, embedded in a mucous sheath. Chlamydospores not observed.
Reference:
Luangsa-ard JJ, Tasanathai K, Thanakitpipattana D, et al. (2018). Novel and interesting Ophiocordyceps spp. (Ophiocordycipitaceae, Hypocreales) with superficial perithecia from Thailand. Studies in Mycology 89: 125–142.
DOI: https://doi.org/10.1016/j.simyco.2018.02.001Species |
Strain |
Compound |
Pubchem CID |
Biological activity |
Reference |
|---|
|
Strain |
|---|